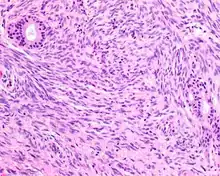

Biphenotypic sinonasal sarcoma
Biphenotypic sinonasal sarcoma is a newly recognized, very rare, low grade malignant tumor of the nasal cavity which was formerly probably included in fibrosarcoma and synovial sarcoma cases. It was incorporated into the fourth edition of the World Health Organization Classification of Head and Neck Tumours, published in 2017.[1]
| Biphenotypic sinonasal sarcoma | |
|---|---|
| Other names | BSNS, LGSSNMF (archaic name) |
![]() | |
| A high power of a hematoxylin and eosin stained slide showing respiratory epithelial inclusions within a spindled cell neoplasm showing characteristics of a biphenotypic sinonasal sarcoma. | |
| Specialty | Oncology, ENT surgery |
| Symptoms | Various upper respiratory symptoms such as difficulty breathing |
| Usual onset | Ages 24-85 (Average of 52 years) |
| Diagnostic method | Biopsy |
| Differential diagnosis | Synovial sarcoma, Fibrosarcoma, and other related sarcomas of the ENT |
| Treatment | Surgery with radiation |
| Prognosis | Good |
| Frequency | Very Rare |
| Deaths | 0 |
Classification
Abbreviations:
- Biphenotypic sinonasal sarcoma (BSNS)
- Original name: Low-grade sinonasal sarcoma with neural and myogenic features (LGSSNMF),[2] but it is no longer recommended.
Definitions:
- A low-grade spindle cell neoplasm of the sinonasal tract associated with overlying respiratory epithelium and showing S100 protein and actin immunoreactivity.
Signs and symptoms
The tumor will often affect multiple sites within the upper aerodigestive tract, frequently showing extension into the orbit (25%) or through the cribriform plate (11%) of the ethmoid sinus into the skull base. The patient presents with non-specific findings, including difficulty breathing, facial pressure, congestion, pain and mild epiphora. Often concurrent benign sinonasal tract inflammatory polyps will be seen.
Diagnosis
Microscopic
- Infiltrative, highly cellular spindled cell neoplasm that is poorly circumscribed and unencapsulated. Bone destruction or invasion is common. The cells show medium to long fascicles (nerve fibers,) with a herringbone pattern. The cells are remarkably uniform with elongated nuclei. There are delicate strands of intercellular collagen without ropy or dense deposition. There is a very characteristic concurrent surface-type respiratory epithelial proliferation from the surface or in small cystic spaces around the cancer cells, often forming glands. The background may have a rich vascularity (vein-ness) and usually has a small number of scattered lymphocytes. Extra growths or mitoses are rare, while necrosis, ulceration, and hemorrhage are usually absent.
Ancillary tests
- S100 protein (Tumor marker protein:) Focal, patchy to diffuse in all tumors.
S100 protein reaction in a biphenotypic sinonasal sarcoma - Smooth muscle actin or muscle specific actin seen in nearly all tumors, but strong and diffuse reaction with SMA is seen in only about 50% of cases.
Smooth muscle actin reaction in a biphenotypic sinonasal sarcoma - No reactivity with other tumor markers such as SOX10, myogenin, estrogen receptor, progesterone receptor, or keratins.
Genetic Testing
- t(2;4)(q35;q31.1): PAX3-MAML3 fusion protein.[3] Only a few cases have shown a PAX3-NCOA1 (inv(2)(q35p23)), and the tumor is negative for SS18-SSX1 or SSX2
Differential diagnoses
- Fibrosarcoma: Can be very similar; although, nerve fibers and herringbone pattern tend to be longer and more well developed
- Synovial sarcoma: Almost histologically identical, but genetic translocation (SS18-SSX1 or SSX2) will be shown through FISH or RT-PCR.
- Malignant peripheral nerve sheath tumor such as triton tumor: Distinctive alternating light and dark cellular areas; association with peripheral nerves; usually a high-grade tumor with pleomorphism, necrosis, and increased mitoses. Generally shows reactivity with S100 protein and SOX10 while negative: SMA, MSA
- Leiomyosarcoma: Fascicular (nerve tract) architecture, with cigar-shaped nuclei showing blunt ends, perinuclear halos (cellular nuclear shrinking,) and eosinophilic cytoplasm. Much stronger reactivity with desmin and SMA, while usually negative with S100 protein.
- Mucosal melanoma: Also a spindled cell tumor in many cases, but there is pleomorphism (more variety in shape/size of tumor cells,) intranuclear inclusions and prominent nucleoli. The neoplastic cells are usually strongly reactive with S100 protein, SOX10, HMB45, Melan-A, tyrosinase, while negative for SMA, MSA.
Epidemiology
As it is newly described, this tumor is probably under-reported, though it is considered to be very rare. Patients present over a wide age range (24–85 years), with a mean age of 52 years. There are more females diagnosed than males (3:1).
Management
- Surgery, often accompanied by radiation, is the treatment of choice. There is frequent (44%) local recurrence but often many years after the initial presentation. As of 2012, there are no regional or distant metastases reported, and no patient has yet died from disease.[2]
References
- Phillips, C. D.; Shatzkes, D.; Dean, K. E. (2019-02-14). "Imaging Review of New and Emerging Sinonasal Tumors and Tumor-like Entities from the Fourth Edition of the World Health Organization Classification of Head and Neck Tumors". American Journal of Neuroradiology. doi:10.3174/ajnr.A5978. ISSN 0195-6108. PMID 30765377.
- Lewis JT, Oliveira AM, Nascimento AG, Schembri-Wismayer D, Moore EA, Olsen KD, Garcia JG, Lonzo ML, Lewis JE (April 2012). "Low-grade sinonasal sarcoma with neural and myogenic features: a clinicopathologic analysis of 28 cases". Am J Surg Pathol. 36 (4): 517–25. doi:10.1097/PAS.0b013e3182426886. PMID 22301502.
- Wang X, Bledsoe KL, Graham RP, Asmann YW, Viswanatha DS, Lewis JE, Lewis JT, Chou MM, Yaszemski MJ, Jen J, Westendorf JJ, Oliveira AM (July 2014). "Recurrent PAX3-MAML3 fusion in biphenotypic sinonasal sarcoma". Nat Genet. 46 (7): 666–8. doi:10.1038/ng.2989. PMC 4236026. PMID 24859338.
